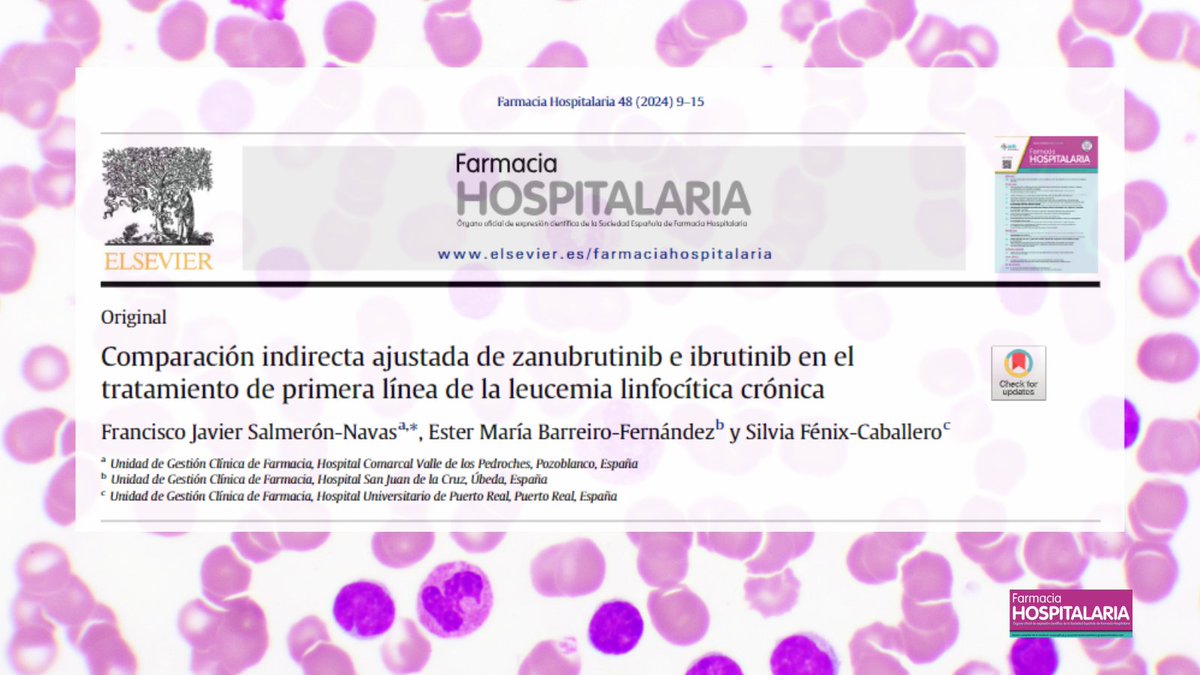
Comparación indirecta ajustada de zanubrutinib e ibrutinib en el tratamiento de primera línea de la leucemia linfocítica crónica <a href="/silfenix7/">Silvia Fénix</a> #RevistaFarmaciaHospitalaria #HospitalPharmacy revistafarmaciahospitalaria.es/es-comparacion…

Vanessa Domínguez
@vanedole
ID: 701161842
17-07-2012 14:36:15
596 Tweet
191 Followers
248 Following

PRIMER PREMIO al trabajo “Mutaciones en el Gen Ugt1a1 y seguridad de sacituzumab-govitecan en el tratamiento del cáncer de mama TNM”, estudio multicéntrico en el que colabora Farmacia Morales Meseguer Área 6 Vega Media Tendiendo Puentes #tendiendopuentes

🗣 Seguimos con la presentación de nuestros finalistas, desde Murcia nos llega la propuesta 'A pie de sillón'. 🛋 Vanessa Domínguez, Eva Garcia, Jose Carlos Titos, Josefa Leon, Mª del Carmen Sola, José Joaquín Nicolas, Pedro Brocal y Mª Amor Caravaca son un grupo multidisciplinar. 👇🏼👇🏼


Comparación indirecta ajustada de zanubrutinib e ibrutinib en el tratamiento de primera línea de la leucemia linfocítica crónica Silvia Fénix #RevistaFarmaciaHospitalaria #HospitalPharmacy revistafarmaciahospitalaria.es/es-comparacion…

Excelente presentación de Biel Mercadal en proyecto Universo_Fharma #innovacion #pacientes #InteligenciaArtificial ALGOPROMIA nuevos modelos de atención basada en #tecnología 💫


Historias de #pacientes contadas del revés en Universo_Fharma por los compañeros del Farmacia Morales Meseguer Atención basada en la #persona 🤓


Carlos Cortés Sánchez presenta el ##PROA #data center en Universo_Fharma ejemplo de trabajo en #equipo para la mejor gestión de la terapia anti infecciosa 🙌🏻


Goyo Romero presenta “Farma Desprec” Haciendo de la necesidad una virtud… Universo_Fharma #thinkdifferent ✍🏻🧠


Mucho #talento #farmaciahospitalaria reunido en el debate Universo_Fharma GRACIAS Boehringer Ingelheim Fundacion BIOTYC S.E.F.H por hacerlo posible y a todos los que habéis participado a lo largo de este camino!


Eva Villaver en este #universo no hay certezas… Universo_Fharma y de cómo la #astrofísica nos enseña a pensar diferente ☄️💫


Nos volvemos de Universo_Fharma con el orgullo de ser finalistas y agradecidas de la oportunidad de contar nuestro proyecto "a pie de sillón"! Enhorabuena a los ganadores FarmaCHUSLab Anxo Fernández Ferreiro 💊 y a todos los finalistas


Un gran ejemplo de atención especializada, empatía y cercanía por parte de los farmacéuticos a los pacientes en los momentos más delicados de su tratamiento 💊. Enhorabuena por lo que habéis logrado Farmacia Morales Meseguer y por cumplir tu sueño Vanessa Domínguez 🚀

Gran dia ayer en Universo_Fharma S.E.F.H Fundacion BIOTYC La innovación debe ser colaborativa, multidisciplinar... 🌟"Si quieres ir rápido camina solo, si quieres llegar lejos ve acompañado ..." 🔝👇 FarmaCHUSLab Goyo Romero Anxo Fernández Ferreiro 💊 Cristina Mondelo Vanessa Domínguez PROA Hospital G. de Requena


Resaca emocional Universo_Fharma ! Que alegría poder compartir Del Revés nuestra experiencia! Que grande que personas diferentes innoven desde lugares diferentes! Orgullo de compañeros Anxo Fernández Ferreiro 💊 Biel Mercadal PROA Hospital G. de Requena Carlos Cortés Sánchez Goyo Romero Gracias a todos!


Biomarcadores clásicos y emergentes y nuevas estrategias de tratamiento en cáncer de mama 21 febrero. 16:15h Alberto Espuny #JesusMariaAcosta #JoseLuisAlonso Mª Sacra Díaz #EvaMGarcia #MonicaMartinez @murciasalud Área 1 Arrixaca @Area2Cartagena Área 6 Vega Media S.E.F.H SEOM SEAP-IAP


Hoy, 22 de febrero 2024, hemos disfrutado de una fantástica jornada sobre biomarcadores y nuevas estrategias de tratamiento en cáncer de mama con unos ponentes de lujo y el patrocinio de Daiichi Sankyo España y AstraZeneca España Gracias a ponentes, asistentes, técnicos y patrocinadores


II Congreso #somufarh2024 📚Hacia una #FarmaciaHospitalaria personalizada 📅31 mayo 📍Universidad Politécnica de Cartagena | UPCT Mesa: Atención Farmacéutica, Calidad, Innovación y Humanización ⏰10:15 ➡️Joaquín Plaza Aniorte ➡️Emilio Monte ➡️Bego Tortajada ➡️Mar Galindo Rueda Inscripciones: congreso2.somufarh.es/inscripcion/


II Congreso de la #SOMUFARH2024 Hacia una #farmaciahospitalaria personalizada 📅31 mayo 📍 Universidad Politécnica de Cartagena | UPCT El Dr. Joaquín Plaza Aniorte del Farmacia Morales Meseguer os invita a la mesa inaugural 📚 Atención Farmacéutica, Calidad, Innovación y Humanización Inscripciones 👇 congreso2.somufarh.es/inscripcion/

El proyecto "Del Revés" de nuestro Servicio ganador del tercer premio de la III Jornada Construyendo la Farmacia Hospitalaria 👏🏻. #CFH25 Murciasalud Área 6 Vega Media SOMUFARH


